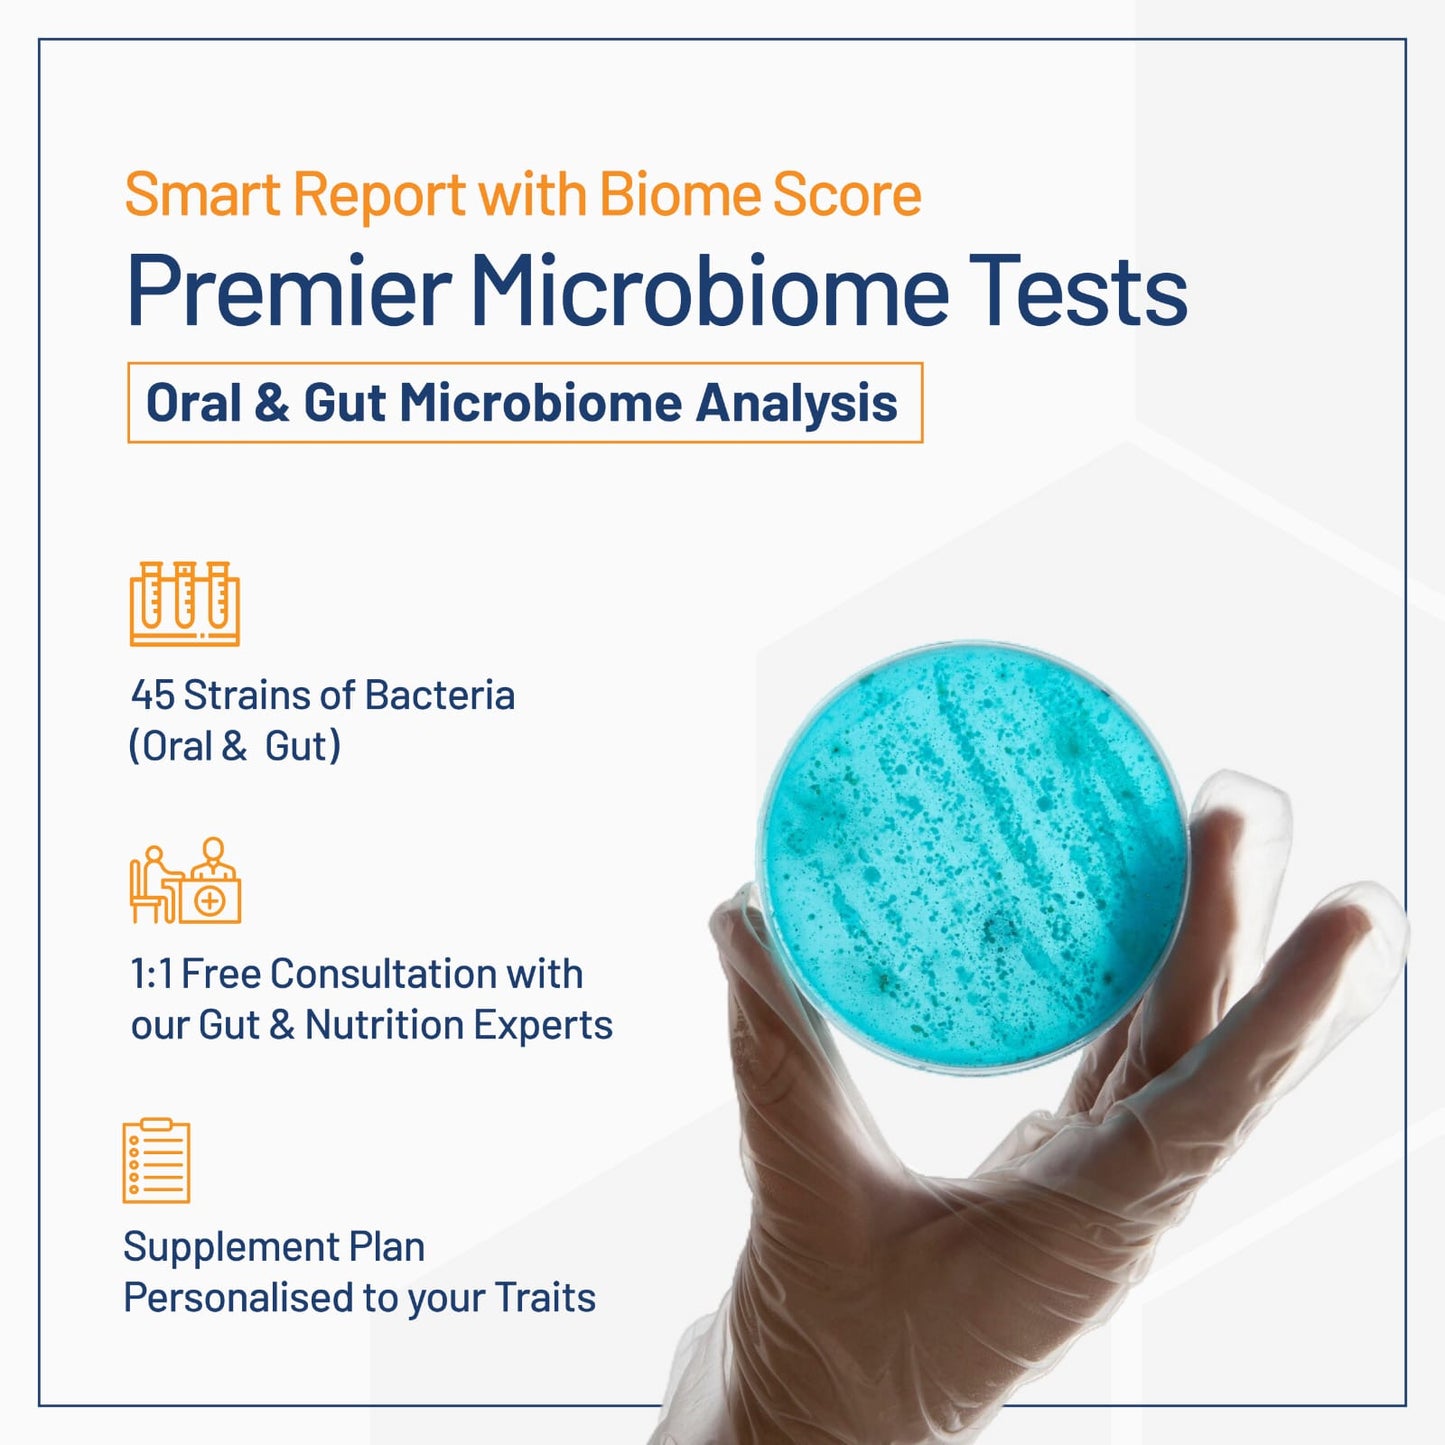

-
Step 1
Arrange Your At-Home Test :
schedule a convenient time for our technician to collect samples from your home, including blood, stool, urine, and oral swabs.
-
Step 2
Receive Your Comprehensive Health Report :
After sample collection, we conduct an in-depth analysis to produce a detailed health report which will be sent directly to you.
-
Step 3
Personalize Your Dietary Supplements:
We create personalized dietary supplements based on your health report, including prebiotics, probiotics, vitamins, minerals, and natural nutrients.
-
Step 4
Enjoy Home Delivery :
Stress-free and convenient, your personalized dietary supplements will be shipped directly to your home, completing the end-to-end at-home service experience.

Get a Glimpse of What's Inside Your Report!
“The road to health is paved with good intestines!”― Sherry A. Rogers